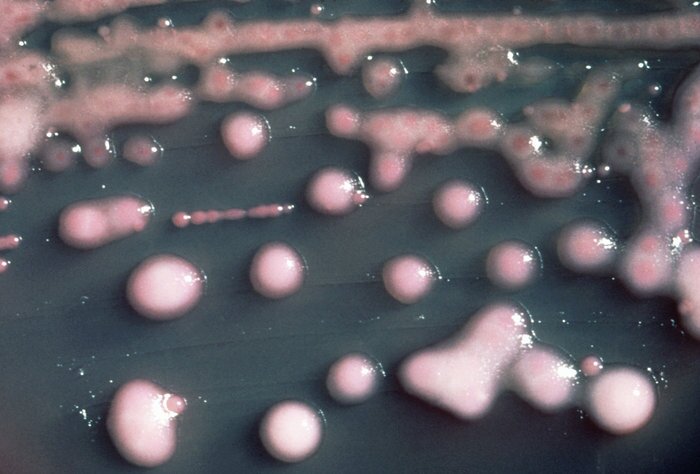

Yesterday we reported on a story about the spread of an anti-biotic resistant bacteria at UCLA's Ronald Reagan Medical Center in Los Angeles.
A type of bacteria known as CRE possibly infected 179 people, and it may be responsible for two deaths. It's been traced to the use of endoscopes, a medical device that can be extremely difficult to clean thoroughly. But, the spread of superbugs is nothing new, as similar incidents involving CRE have occurred recently at hospitals in Seattle, Chicago and Pittsburgh. And procedures for handling this infection and others are being practiced by hospitals but it is far from routine.
Dr. Alex Kallen from the Centers of Disease Control has helped investigate the issue and he joins Tess Vigeland to talk about the issue.